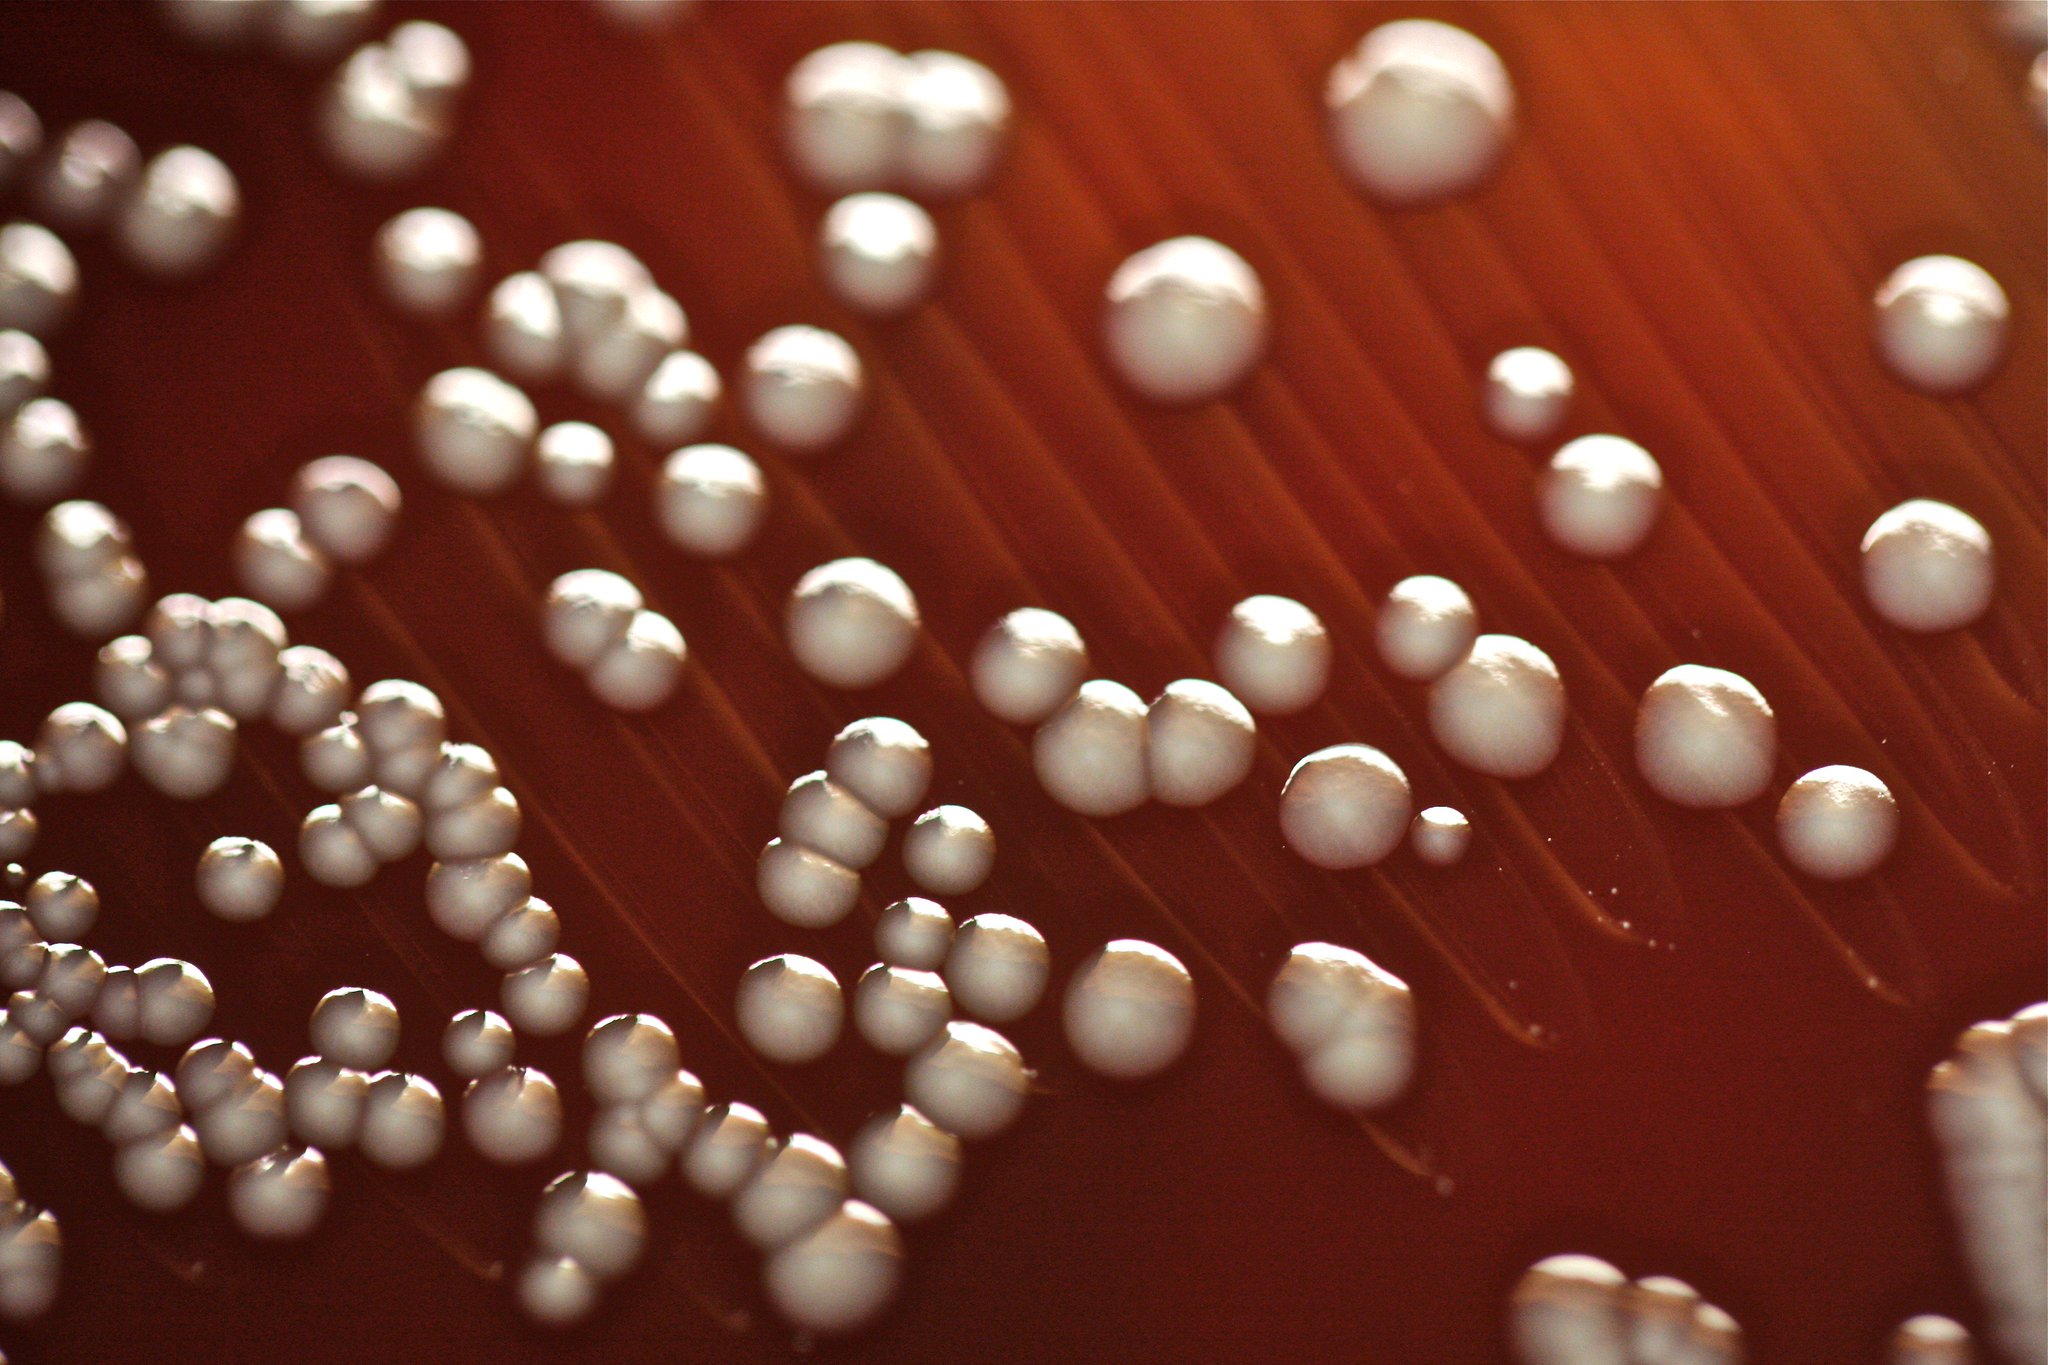
Tasha Sturm on Twitter: "Glistening colonies of Enterobacter aerogenes

If you are looking for Chryseobacterium indologenes and actinomycete colonies on Mueller you've came to the right place. We have 9 Pictures about Chryseobacterium indologenes and actinomycete colonies on Mueller like Terrestrial Bacteria from Agricultural Soils: Versatile Weapons against, Bacterial Colonies & Streak Plate: Free Images & Photographs from and also Bacterial Colonies & Streak Plate: Free Images & Photographs from. Read more:
Chryseobacterium Indologenes And Actinomycete Colonies On Mueller
 pinterest.com
pinterest.com colonies chryseobacterium hinton mueller actinomycete microbiology klebsiella
MacConkey Agar: Composition, Preparation, Uses And Colony
 microbeonline.com
microbeonline.com macconkey agar lactose non fermenting characteristics preparation mac colony coli fermenter colonies colorless fermentation proteus fermenters medium mirabilis aureus composition
Bacteria On Blood Agar - A Set On Flickr
agar blood flickr
Tasha Sturm On Twitter: "Glistening Colonies Of Enterobacter Aerogenes
twitter.com
twitter.com enterobacter aerogenes glistening tasha sturm
Pseudomonas | Certain Bacteria Are Able To Produce A Diffusa… | Flickr
 www.flickr.com
www.flickr.com pseudomonas
Staphylococcus Bacteria Free Images & Photographs From Science Prof Online
 www.scienceprofonline.com
www.scienceprofonline.com staphylococcus science colony msa morphology bacteria library microbiology scienceprofonline
Bacterial Colony Morphology And Identification Of Bacteria
 www.scienceprofonline.com
www.scienceprofonline.com plate streak micrococcus luteus colony bacteria bacterial colonies microbiology agar morphology science tryptic soy library identification yellow unknown round contamination
Bacterial Colonies & Streak Plate: Free Images & Photographs From
 www.scienceprofonline.com
www.scienceprofonline.com bacterial bacteria growth plate plates colony colonies liquid growing nutrient broth science microbiology morphology touch identification agar lab culture streak
Terrestrial Bacteria From Agricultural Soils: Versatile Weapons Against
 www.intechopen.com
www.intechopen.com bacteria fungi colonies terrestrial colony types soils agricultural versatile weapons against intechopen figure
Tasha sturm on twitter: "glistening colonies of enterobacter aerogenes. Bacterial bacteria growth plate plates colony colonies liquid growing nutrient broth science microbiology morphology touch identification agar lab culture streak. Colonies chryseobacterium hinton mueller actinomycete microbiology klebsiella